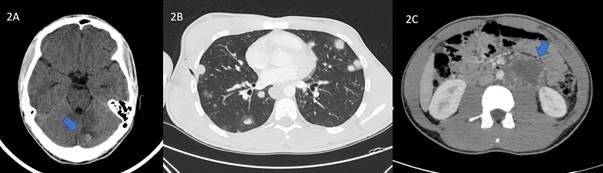
A) TAC craneal donde se objetiva una lesi&oacute;n nodular hiperdensa en la regi&oacute;n occipital izquierda con discreto edema, sin efecto de masa, sugerente de met&aacute;stasis. B) TAC tor&aacute;cico: a nivel del par&eacute;nquima pulmonar se observan m&uacute;ltiples n&oacute;dulos redondeados, s&oacute;lidos y con un ligero halo alrededor que ocupan ambos campos pulmonares, muchos de ellos subpleurales. C) TAC abdominal: a nivel retroperitoneal se identifica una lesi&oacute;n heterog&eacute;nea, predominantemente hipodensa, de bordes lobulados y captaci&oacute;n perif&eacute;rica con &aacute;reas de necrosis en relaci&oacute;n con conglomerado adenop&aacute;tico.

UN PACIENTE CON…
Vómitos
Vomiting
Vómitos
Revista Clínica de Medicina de Familia, vol. 13, núm. 3, 2020
Sociedad Castellano-Manchega de Medicina de Familia y Comunitaria
Recepción: 23 Marzo 2019
Aprobación: 24 Septiembre 2019
RESUMEN: Los vómitos son un motivo frecuente de consulta. La mayoría de las veces se deben a enfermedades benignas; sin embargo, pueden ser el síntoma inicial de patologías graves y complejas, como procesos neoplásicos con afectación del sistema nervioso central, donde son el resultado del aumento de la presión intracraneal. El cáncer de testículo representa aproximadamente el 1 % de todas las neoplasias y constituye la neoplasia maligna más frecuente en hombres de entre 15 y 34 años. El coriocarcinoma supone entre el 0,3 y el 1 % de las neoplasias testiculares; es considerado como el más raro y con peor pronóstico de todas debido a su rápida diseminación. La mayoría de los casos debutan con síntomas en relación con las metástasis. Presentamos el caso de un paciente de 16 años que acude a consulta por mareos y vómitos. Presentaba una auscultación pulmonar patológica, por la que se solicitó una radiografía torácica que mostró neumotórax derecho e imagen en suelta de globos. Al ampliar estudio, se objetiva una B-HCG elevada y lesión nodular en la ecografía testicular. En el TAC cerebral se objetivaron lesiones metastásicas responsable de los vómitos. Se realizó biopsia de una lesión ulcerada del cuero cabelludo que informó metástasis de coriocarcinoma testicular.
PALABRAS CLAVE: Vómitos, Coriocarcinoma no Gestacional, Neoplasias Testiculares.
ABSTRACT: Vomiting is a frequent complaint. Most times it is caused by benign conditions. However, it can also be the initial symptom of serious and complex illnesses, such as neoplastic processes with central nervous system involvement, where vomiting is the result of increased intracranial pressure. Testicular cancer accounts for 1% of all neoplasms, and is the most frequent malignancy in men between 15 and 34 years. Choriocarcinoma accounts for 0.3-1% of testicular neoplasms, and it is considered the rarest of all and the one with the worst prognosis due to rapid spread. Most cases begin with symptoms related to the metastases. We present the case of a 16-year-old patient with dizziness and vomiting. His pulmonary auscultation was pathological, so a chest x-ray was performed, showing right pneumothorax and multiple pulmonary nodules. Further study showed elevated B-HCG and a nodular lesion in testicular ultrasound. Metastatic lesions responsible for the vomiting were found in the brain CT. A biopsy of an ulcerated lesion of the scalp showed metastasis of testicular choriocarcinoma.
KEY WORDS: Vomiting. Choriocarcinoma, Non-gestational. Testicular Neoplasms.
INTRODUCCIÓN
El cáncer de testículo representa aproximadamente el 1 % de todas las neoplasias y constituye la neoplasia maligna más frecuente en hombres de entre 15 y 34 años1,2. Al momento del diagnóstico, el 69 % de ellos se encuentran localizados, el 18 % son regionales y el 12 % presenta afectación metastásica2. Se clasifican en seminomatosos y no seminomatosos. Los primeros son radiosensibles y se diseminan por vía linfática, mientras que los no seminomatosos suelen metastatizar por vía hematógena y son radiorresistentes1. Estos últimos se clasifican a su vez, en carcinoma de células embrionarias, coriocarcinoma y teratoma.
CASO CLÍNICO
Varón de 16 años, diabético tipo 1 en tratamiento con insulina, que acude a consulta por un cuadro de tres días evolución caracterizado por mareos, náuseas y vómitos alimentarios. Negaba fiebre o clínica miccional. Se encontraba hemodinámicamente estable con una presión arterial de 100/69 mm Hg; a la auscultación se objetivaron ruidos cardiacos rítmicos, aunque ligeramente taquicárdicos a 98 latidos por minuto y disminución del murmullo vesicular en el ápice pulmonar derecho, sin ruidos agregados y con saturación de oxígeno de 98 %. La exploración abdominal era anodina. Dada la alteración en la auscultación pulmonar, fue remitido al servicio de urgencias hospitalarias.
Se realizó analítica básica: el hemograma mostraba leucocitosis de 13 900 con neutrofilia y sin anemia. La glucosa era de 219 mg/dl con iones y función renal normales. La PCR era de16 mg/l. En la radiografía de tórax se apreciaba un neumotórax derecho de un 40 % y una imagen en suelta de globos en ambos campos pulmonares (Figura 1A). Se colocó un tubo de drenaje endotorácico. Dado el hallazgo radiológico, realizamos exploración de genitales sin objetivar ninguna alteración; sin embargo, dadas las características del caso, se solicitó una beta-HCG urgente, obteniéndose un valor de 89 900 mUI/ml. Se realizó una ecografía testicular donde apreciamos una lesión pseudonodular en el testículo izquierdo de 8 x 9 mm con presencia de microcalcificaciones y vascularización intratesticular sugestivo de proceso neoformativo primario (Figura 1B). Se decidió ingreso hospitalario para ampliación de estudio.

La radiografía torácica de control evidenció una adecuada re-expansión pulmonar. Se ajustó la pauta de insulina alcanzando un adecuado control glucémico; sin embargo, el paciente persistía con mareos y vómitos. Se solicitó un TAC craneal urgente donde se objetivaron 3 lesiones nodulares hiperdensas en la región frontal, occipital y cerebelosa izquierdas, sin edema ni efecto de masa, sugerentes de metástasis (Figura 2A). Posteriormente, se re-exploró al paciente observando una pequeña lesión ulcerada con discreto sangrado en el cuero cabelludo. El paciente lo identificó como un “grano” que había notado desde hacía una semana aproximadamente. Se tomaron biopsias de dicha lesión que informaron de la presencia de células grandes con núcleo vesiculoso atípico y amplio citoplasma con numerosas células multinucleadas intercaladas (sincitio) así como extensas áreas de hemorragia y numerosas mitosis, concluyendo el diagnóstico de metástasis de coriocarcinoma. Como parte del estudio de extensión, se realizó un TAC tóraco-abdominal donde se apreció un importante conglomerado adenopático retroperitoneal (Figura 2B y 2C). El diagnóstico final fue de coriocarcinoma testicular metastásico con afectación pulmonar, cerebral y adenopática.
DISCUSIÓN
El coriocarcinoma supone entre el 0,3 y el 1 % de las neoplasias testiculares, es considerado como el más raro y con peor pronóstico de todas2,3. Deriva de las células totipotenciales del testículo y es altamente agresivo, presenta una amplia diseminación en estadios precoces en los que la clínica testicular suele estar ausente3. Los sitios de afectación metastásica más frecuentes son los pulmones, cerebro, ganglios retroperitoneales y hasta el sistema digestivo1,2,4. La mayoría de los casos debutan con síntomas en relación con las metastásis3, como cefalea intensa asociada a alteraciones visuales, vértigo o vómitos por afectación del sistema nervioso central1. También son frecuentes la hemoptisis secundaria a metástasis pulmonares o dolor de espalda por extensión retroperitoneal3. Puede presentarse ginecomastia e incluso tirotoxicosis en relación con niveles elevados de beta-HCG2,3,5. Sin embargo, es extremadamente raro encontrar siembras de esta estirpe tumoral en la piel3,4, se estima que está presente solo en el 0,4 % de los casos y se localiza principalmente en el cuero cabelludo y con menor frecuencia en la pared torácica o abdominal4,6. La presentación es muy variada, lo más frecuente son nódulos asintomáticos de aparición brusca y crecimiento rápido, de 1 a 4 cm de diámetro, de consistencia duro-elástica, leñosa y con posibilidad de ulcerarse6. Histológicamente, el coriocarcinoma está constituido por dos estirpes celulares: el citotrofoblasto y el sincitiotrofoblasto; este último es el responsable de la secreción de beta-HCG. El tratamiento es la orquitectomía radical asociada a quimioterapia basada en la combinación de bleomicina, etopósido y cisplastino; sin embargo, existen escasas comunicaciones de remisión2,3. La beta-HCG permite monitorizar la respuesta al tratamiento: valores persistentemente elevados se asocian a tumor residual o recurrencias4. En casos refractarios puede realizarse terapia de rescate con altas dosis de quimioterapia y trasplante autólogo de células madre hematopoyéticas5.
Los vómitos son un motivo frecuente de consulta; la mayoría de las veces se deben a patologías benignas. Sin embargo, pueden ser el síntoma inicial de una patología grave y compleja. Una exploración física completa y minuciosa es capaz de distinguir alteraciones muy sutiles que determinarán las pruebas complementarias a solicitar. En nuestro caso, tras lo evidenciado en la radiografía torácica, se solicitó la beta-HCG, cuyo resultado fue prácticamente diagnóstico. De la misma forma, la posibilidad de realizar una ecografía a pie de cama del paciente en urgencias o Atención Primaria, permiten confirmar de forma precoz un diagnóstico tan complejo como el de neoplasia testicular. El desarrollo de la ecografía clínica permite al médico de familia responsable del paciente complementar el proceso diagnóstico y resolver problemas médicos concretos con una alta rentabilidad. Esta situación acorta los tiempos de estudio y facilita un rápido inicio del tratamiento.
BIBLIOGRAFÍA
1. Cumming A, Balanzario-Cuevas J, Vitar-Sandoval J, Monjaras-Guerra J, Rodríguez-Robles J, Cortés-Tapia I et al. Coriocarcinoma testicular con metástasis a coroides. Rev Mex Urol. 2016; 76 (6): 387-91.
2. Lin D, Tan AJ, Singh-Rai R. A literature review and case report of metastatic pure choriocarcinoma. Case Rep Oncol Med. 2015; 2015: 345018.
3. Torres-Gómez F, Torres-Olivera FJ, Díaz Delgado M. Coriocarcinoma testicular con patrón histológico puro: estudio necrópsico de un caso representativo. Arch Esp Urol. 2007; 60 (3): 287-90.
4. López Santoro MC, Gómez Carril MM, Arias M, Abeldaño A, Kien C, Pellerano G. Metástasis cutáneas de coriocarcinoma secundarias a tumor germinal mixto testicular. Dermatol Argent. 2008; 14 (3): 207-10.
5. Gardner F, Wu K, Tan WW. Male choriocarcinoma with pulmonary and liver metastases, choriocarcinoma syndrome, and brain metastasis: a case report and review of the literature. Ann Hematol Oncol. 2014; 1 (1): 1003.
6. Delpero G, Obeid Pedemonte R, Depetris S, Aybar I, Salazar de Talamazzi S. Metástasis cutánea de carcinoma de testículo. A propósito de un caso. Arch Argent Dermatol. 2005; 55: 203-6.
Notas de autor
Correspondencia: Verónica Notario Barba. Hospital Nuestra Señora del Prado. Ctra. Madrid, Km. 114. C.P. 45600 - Talavera de la Reina. Toledo (España). Correo electrónico: vero_not@hotmail.com